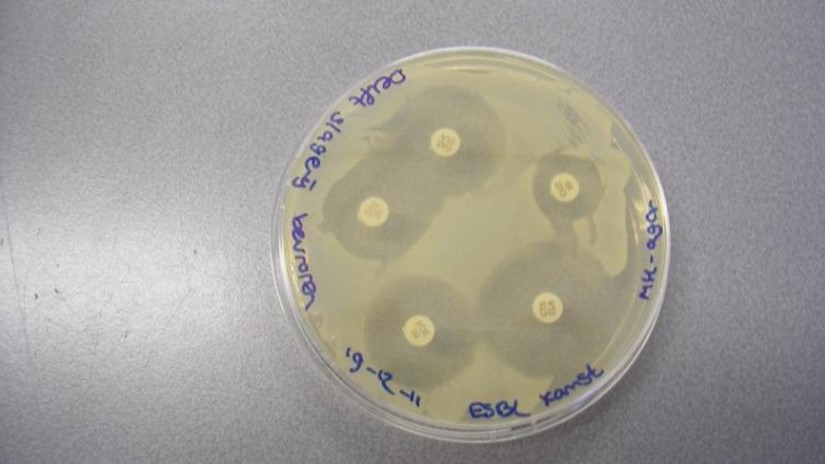

Vraagstelling
Derdejaars studenten van de opleiding BML-research hebben getest of op kippenvlees uit de supermarkt en uit een biologische slagerij E. coli bacteriën konden worden aangetoond die resistent zijn tegen een grote groep van antibiotica. Virtuele opdrachtgever was de overheid die wil weten of op kippenvlees dezelfde resistente bacteriën voorkomen als bij de mens. Als dat veelvuldig voorkomt, zal de overheid een nog strenger beleid moeten gaan voeren om overmatig antibiotica gebruik in de kippenhouderij te beperken.
Aanpak
Op kippenfilet van zowel supermarkten als van een biologische slagerij werd flink wat resistente bacteriën aangetroffen. Dit werd aangetoond met bacteriekweken, en met een DNA-techniek, de zogenaamde PCR. De heldere zone rond de papiertjes op de kweekschaal op foto 1, en de lichte streepjes in het midden op foto 2 duiden op aanwezigheid van resistente bacteriën.
Resultaat
De studenten hebben bij dit project geleerd hoe verschillende typen resistente bacteriën kunnen worden aangetoond, en dat deze bacteriën inderdaad ruimschoots voorkomen op kippenvlees in de winkel. Wat natuurlijk ook al eerder beschreven is in de media door professionele onderzoekers op dit gebied.
Opleiding(en)
- Biologie en Medisch Laboratoriumonderzoek
Type
Project
Begeleider(s)
Eric Kamst, O.P. Middelkoop